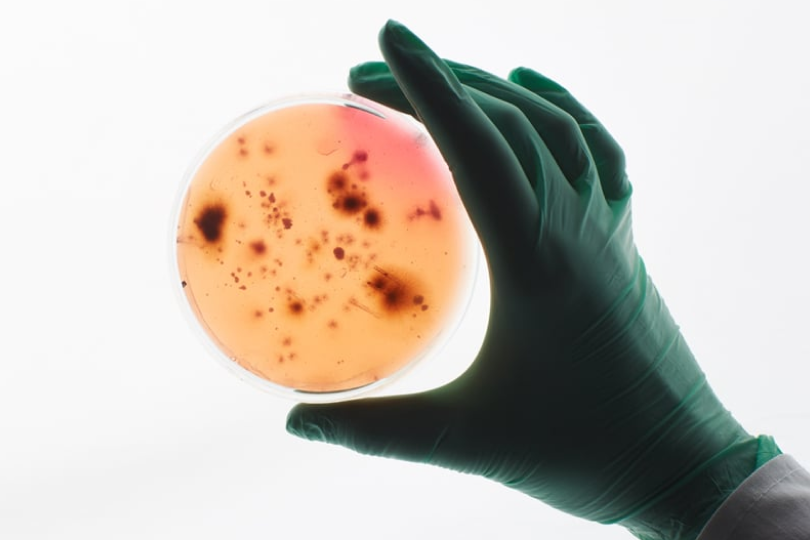

At Life-Space, we are dedicated to unlocking the science of the microbiome and the important role it plays in building and maintaining good health.
As Australia’s no. 1 probiotic brand*, we transform complex microbiome science into accessible solutions that help people take control of their health, grounded in research with strains backed by over 50 clinical trials
Championing innovation in probiotics
Recent decades have seen a huge increase in our understanding of the microbiome, but much remains to be discovered.
As we explore this fascinating world, we become capable of understanding processes that were once a mystery.
Our resident microbes don’t just help us to digest our food, but can influence our emotional, mental, dermatological, and nutritional wellbeing.
Driven by research on the microbiome
Research has uncovered that our microbiome - the trillions of microbial cells living in and on us - is intricately linked to almost every process in our body.
Our passionate belief is that the next frontier in wellness will come from looking within and exploring the amazing, complex world of our microbiome.
.jpg?v=1776147326264)